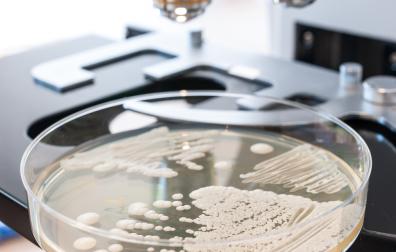
Microscoop met bakje met schimmels

FTO Dermatomycosen
Schimmelinfecties van huid, haren en nagels
Het aantal schimmelinfecties neemt in rap tempo toe. De ongevaarlijke, maar vaak hinderlijke varianten, de dermatomycose, zijn zichtbare afwijkingen van nagels, haren of huid. Dermatomycosen behoren tot de kleine veelvoorkomende kwalen. Dit betekent dat patiënten de klacht in meer dan 75 procent van de gevallen zelf kunnen oplossen. Toch krijgen patiënten nog vaak een receptgeneesmiddel voorgeschreven.
Zelfzorgmiddelen
De FTO-module over dermatomycosen en zelfzorg informeert huisartsen en apothekers over de beschikbare zelfzorgmiddelen en hun toegevoegde waarde, maar ook wanneer een recept voor een (zelfzorg)geneesmiddel de voorkeur heeft. Het is niet altijd duidelijk wanneer een recept voor geneesmiddelen de voorkeur heeft.
In het FTO kunnen huisartsen en apothekers gezamenlijk afspraken maken over het bevorderen van de zelfredzaamheid van de patiënt en de inzet van zelfzorgmiddelen bij dermatomycosen.
De module
In deze FTO-module komen de volgende onderwerpen aan bod:
- inzicht in het aanbod van zelfzorgmiddelen voor patiënten met dermatomycosen
- het niet-medicamenteuze en medicamenteuze (zelfzorg)beleid bij dermatomycosen
- hoe een zelfzorgadvies de zelfredzaamheid van patiënten met dermatomycosen kan bevorderen
- afspraken over het zelfzorgbeleid en de voorlichting bij dermatomycosen
Dit onderwerp agenderen voor uw volgende FTO?
